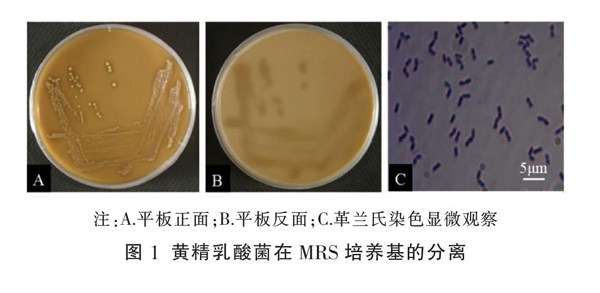

黄精发酵体系中植物乳杆菌的分离鉴定和MTT法活菌快速检测研究

打开文本图片集
〔摘要〕 目的 从黄精发酵体系中分离鉴定益生菌,并建立其快速检测方法。方法 通过形态学观察、革兰氏染色、16S rRNA基因序列测定和同源性分析对分离的菌株进行鉴定,采用MTT法建立快速检测方法。结果 从鲜黄精发酵体系中分离获得一株乳酸菌,鉴定为植物乳杆菌(Lactobacillus plantarum);建立了植物乳杆菌检测的MTT法,发现检测最佳波长为545 nm,适宜染色时间为2 h,最低检测度为活菌浓度为107 CFU/mL,在活菌浓度为7×107~3×108 CFU/mL范围内,植物乳杆菌样品活菌浓度与545 nm处OD呈现良好的线性关系。(剩余9141字)